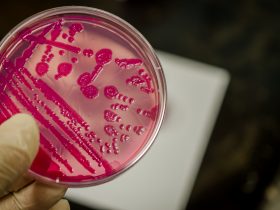
Placa de cultura bacteriana Por manjurulhaque

A desinformação nas plataformas digitais está influenciando significativamente a percepção dos brasileiros sobre a segurança e eficácia das ...
Duas estudantes de engenharia biomecânica do Instituto Nacional de Telecomunicações (Inatel), em Minas Gerais, Beatriz Scárdua e Thayana ...
Cientistas do Reino Unido fizeram uma descoberta significativa sobre a Doença Inflamatória Intestinal (DII). Eles encontraram uma alteração ...
Pesquisadores do Instituto Butantan descobriram um novo alvo para o tratamento da esclerose múltipla (EM) usando uma proteína ...
Nesta quarta-feira, o Instituto Brasileiro de Defesa do Consumidor (Idec) apresentou uma nova pesquisa destacando a presença de ...
O grupo de estudo internacional Global Burden of Diseases (Carga Global das Doenças) acaba de publicar um novo ...
Pesquisadores chineses desvendaram o comportamento cerebral durante interações entre líderes e seguidores. Eles descobriram que o cérebro dos ...
Um estudo abrangente, conduzido por especialistas do Cidacs/Fiocruz Bahia, revelou uma preocupação importante para a saúde materno-infantil: a ...
Pesquisadores da Irlanda e do Japão alertam para os perigos dos vaporizadores aromatizados, revelando que os produtos químicos ...
A espera angustiante pelos resultados de culturas bacterianas em fluidos biológicos pode se tornar uma relíquia do passado, ...